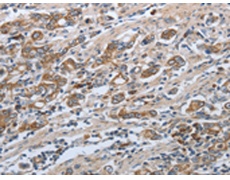
一抗

|
Background: |
The protein encoded by this gene is a pH-sensitive sodium-dependent phosphate transporter. Phosphate uptake is increased at lower pH. Defects in this gene are a cause of pulmonary alveolar microlithiasis. Three transcript variants encoding two different isoforms have been found for this gene. |
|
Applications: |
ELISA, IHC |
|
Name of antibody: |
SLC34A2 |
|
Immunogen: |
Synthetic peptide of human SLC34A2 |
|
Full name: |
Solute carrier family 34 (sodium phosphate), member 2 |
|
Synonyms: |
NPTIIb, NAPI-3B, NAPI-IIb |
|
SwissProt: |
O95436 |
|
IHC positive control: |
Human gastric cancer and human ovarian cancer |
|
IHC Recommend dilution: |
50-200 |

 購物車
購物車 幫助
幫助
 021-54845833/15800441009
021-54845833/15800441009